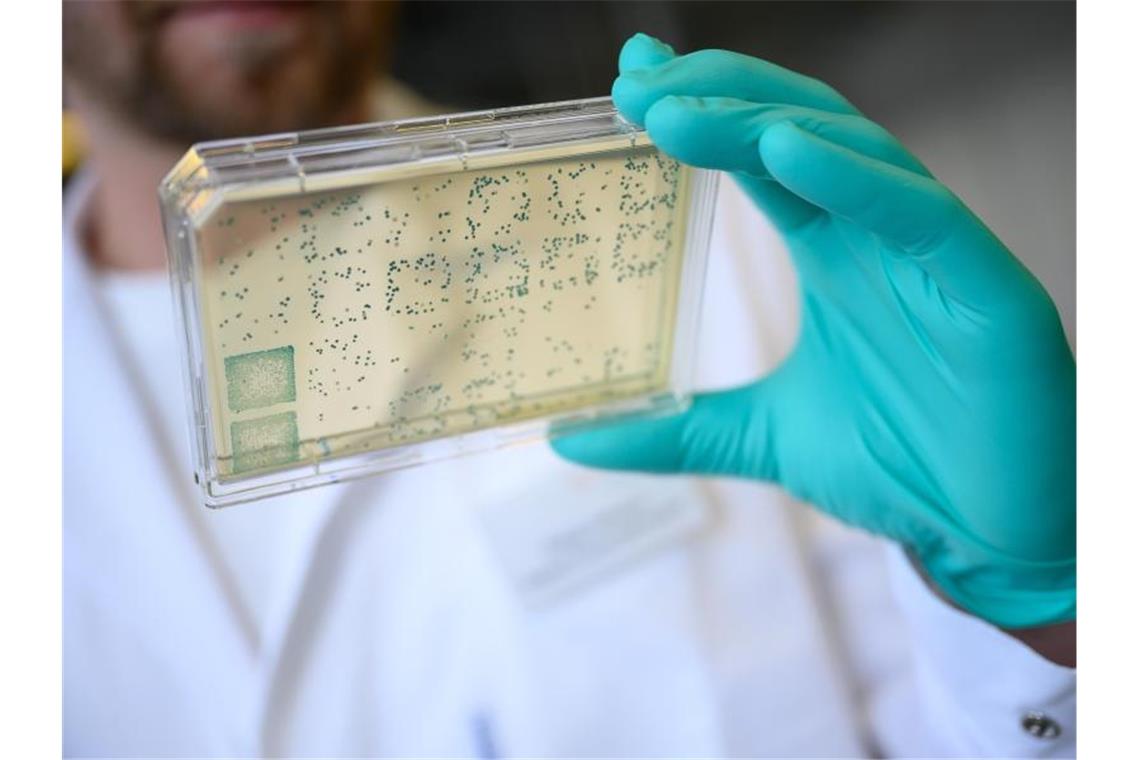

CureVac-Impfstoffkandidat wird in Tübingen getestet
dpa Tübingen. Die erste klinische Studie mit dem Corona-Impfstoffkandidaten der Firma CureVac hat am Donnerstag an der Uniklinik Tübingen begonnen. Die Studie an mehr als 100 Menschen im Alter von 18 bis 60 Jahren wird am Institut für Tropenmedizin, Reisemedizin und Humanparasitologie durchgeführt, wie die Uniklinik mitteilte. Damit wird der Impfstoff im Rahmen einer klinischen Studie zum ersten Mal am Menschen erprobt. Ziel sei es, die Verträglichkeit sowie eine spezifische Immunantwort gegen das Virus zu ermitteln, erklärte der Institutsdirektor und Studienleiter, Professor Peter Kremsner.
Ein Träger mit Bakterien. Foto: Sebastian Gollnow/dpa/Archivbild
CureVac arbeitet an sogenannten mRNA-Impfstoffen. mRNA ist eine Art Botenmolekül, in dem die Bauanleitung zur Herstellung von Proteinen steckt. Für ihren Impfstoff haben die CureVac-Forscher mRNA mit der Bauanleitung für ein Protein des Coronavirus Sars-CoV-2 versehen. Die menschlichen Zellen bilden nach der Impfung dieses Protein, was der Körper als fremd erkennt. Er bildet Antikörper und andere Abwehrzellen dagegen.
Die Studie wird laut Uniklinik in mehreren Phasen ablaufen. Erst soll der Impfstoff den Probanden in der niedrigsten Dosierung von 2 Mikrogramm verabreicht werden. Die Zahl der Teilnehmer sowie die Dosis des Wirkstoffs sollen abhängig von der Verträglichkeit erhöht werden. Im nächsten Schritt - voraussichtlich im Spätsommer - sollen die Altersgrenzen erweitert werden, ebenso soll dann international getestet werden.
Die Genehmigung für die Studie hatte das zuständige Paul-Ehrlich-Institut (PEI) in Langen erteilt. Das Wirtschaftsministerium hatte Anfang der Woche bekanntgegeben, sich mit 300 Millionen Euro an CureVac zu beteiligen und rund 23 Prozent der Anteile zu übernehmen, um sich gegen eine mögliche Übernahme aus dem Ausland abzusichern.